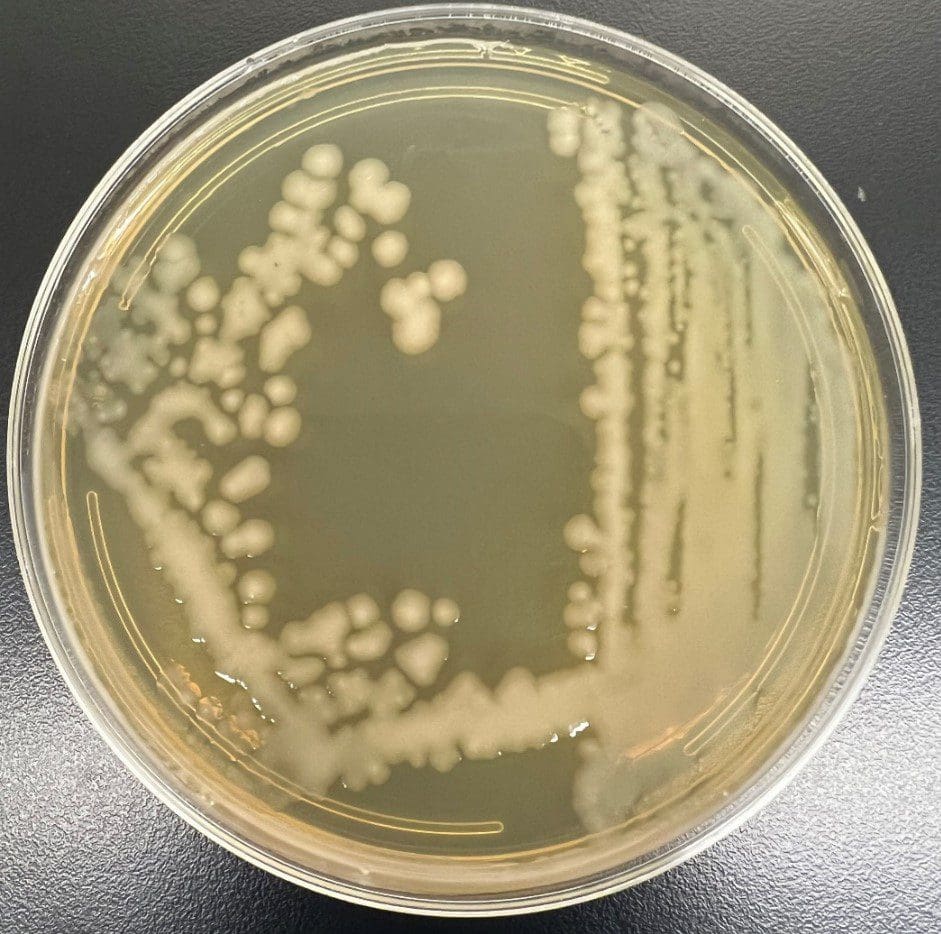
Salmonella-typhii Salmonella typhii

Salmonella Typhi is serovar of S. enteric which is ubiquitous pathogen that affect both human and animals. These bacteria are acquired by the consumption of feces contaminated food or water which infect the intestinal tract and blood and cause disease known as typhoid fever or enteric fever.

Taxonomy and Classification
Classification of Salmonella is a complicated process. The genus consists of mainly two species i.e. Salmonella enteric and Salmonella bongori. Species Salmonella enterica is divided into subspecies based on genomic relatedness and biochemical properties. These subspecies are denoted by Roman numerals: S. enterica subspecies enterica I, S. enterica subspecies salamae II, S. enterica subspecies arizonae III, S. enterica subspecies diarizonae IIIa, S. enterica subspecies houtenae IV, S. enterica subspecies indica V. Among different subspecies, S. enteria subspecies enterica I is most common subspecies which is mainly responsible for about 99% of infections in warm blooded animals and humans. Remaining subspecies and S. bongori predominantly cause infections to cold blooded animals and this subspecies are rarely found in humans. In subspecies I there are 4 serotypes named as: Typhi, Typhimurium, Enteritidis and Choleraesuis. These serotypes are named based on the geographic location from where serotype was first isolated.
Domain: Bacteria
Kingdom: Pseudomonadati
Phylum: Pseudomonadota
Class: Gammaproteobacteria
Order: Enterobacterales
Family: Enterobacteriaceae
Genus: Salmonella
Species: S. enterica
Serotype: Typhi
Morphology and Microscopy
- Gram negative bacilli, rod shaped, 0.7-1.5*2-5µm
- Catalse positive and Oxidase negative
- Non-sporing
- Motile by peritrichous flagella
- Aerobic or facultative anaerobes
Under microscope they are observed as pink rod shaped structure.
Cultural and Growth Characteristics
- Optimum temperature: 37ËšC
- Optimum pH: 6-8
- Aerobic or Facultative anaerobes
- On solid media colonies are round, large, 2-3mm in diameter, smooth, convex, translucent.
- On Nutrient Agar: 2-3mm, moist, off-white, smooth, convex, complete margins.
- On Blood Agar: 2-3mm, off-white, convex, moist, complete margins.
Fig 1: Growth of Salmonella typhi
Source: https://microchemlab.com/microorganisms/salmonella-typhii/
Biochemical and Identification Tests
| Tests | Results |
| Gram Staining | Positive |
| Catalase | Positive |
| Oxidase | Negative |
| Indole | Negative |
| MR (Methyl Red) | Positive |
| VP (Voges Proskauer) | Negative |
| Citrate | Negative |
| H2S | Positive |
| Motility | Motile |
| Gas | Negative |
| Gelatin Hydrolysis | Negative |
| Urease | Negative |
| TSIA | Alkali/Acid |
| Nitrate Reduction | Positive |
| Fermentation of | |
| Glucose | Positive |
| Maltose | Positive |
| Glycerol | Negative |
| Lactose | Negative |
| Mannitol | Positive |
| Dnase | Negative |
| Arabinose | Negative |
| Cellobiose | Negative |
| Sucrose | Negative |
| Enzymatic Reactions | |
| Arginine Dehydrolase | Negative |
| Acetate Utilization | Negative |
| Tyrosine Hydrolysis | Negative |
| Lipase | Negative |
| Lysine | Positive |
| Ornithine Decarboxylase | Negative |
| ONPG (β-galactosidase) | Negative |

Source: https://x.com/Ghazi2014/status/1448257023959838729
Pathogenesis and Virulence Factors
The ingestion of S. Typhi mainly occurs via consumption of contaminated food and water. Then the bacteria adhere to the host cell surface after which internalization occurs either. r via phagocytosis or by active invasion. Phagocytosis mainly involves intricate mechanisms which depend on engagement of numerous receptors, like Pattern Recognition Receptors (PRRs). PRRs comprise cytosolic nucleotide binding receptors and and toll-like receptors (TLRs), that acknowledge pathogen-associated molecular patterns (PAMPs) such as flagellin and lipopolysaccharides (LPS) situated on the cell surface and/or within phagosomes. This appreciation influences the maturation of phagosomes, triggers signaling pathways, and modulates gene expression. Many studies suggest that the interaction between toll-like receptors and lipopolysaccharide plays crucial part in the development of septic shock. In contrast, the typhoidal serovars like S. Typhi avoid appreciation by TLR4, blocking the recruitment of neutrophils and the appearance of pro-inflammatory molecules like TNF-α and interleukin 1β thus blocking a typical antimicrobial reaction in the host cell. The extent of production of the cytokines in human cytokines is similar to that obtained in the non-typhoidal Salmonella. This is the most important step in the incursion of Salmonella and takes place by infiltrating both phagocytic and non-phagocytic cells. Incursion and settlement of Salmonella in host cell depends on the presence of various virulence factors.
There are various virulence factors in Salmonella which is explained below:
Capsular (Vi antigen)
- Is a linear homopolymer of α1-4 connected with galactose aminouronic acid that is acetylated to the position C3.
- It inhibits activation of complement C3 and phagocytosis and thrive resistance against host immune system.
Virulence Plasmid
- Are large and found in low numbers to reduce the strain on the host’s cell metabolism, protecting them from being preserved during cell division.
- Perform essential part by nurturing genes responsible for antimicrobial resistance and posses virulence factors like spcC (blocks pyroptosis and inflammation) and spvB (ADP-ribosylating toxin).
Flagella (H antigen)
- Helps in adhesion, invasion, export of protein and formation of biofilm.
Toxins
- Salmonella Typhi have ability to synthesize toxins causing typhoid fever.
- Belongs to AB toxin group, that possess an enzymatic subunit (A) and a receptor subunit (B).
- Vacuole containing Salmonella disperse toxins from infected cells to the environment permitting it to affect other target cells.
Somatic O antigen (cell wall antigen and LPS)
- LPS possess particular proteins known as outer membrane proteins (OMP) that are antigenic in nature.
- OMP have both porin and non-porin substances. Porins are pore-forming channels that assist in uptake of solute while non-porin proteins are structural proteins.
- Highly immunogenic and shows good antibody response to all antigens in patients having typhoid fever.
Superoxide Dismutase
- Group of enzymes which catalyzes the transformation of superoxide radicals into molecular oxygen and hydrogen peroxide.
Biofilms
- Formation of biofilms is the adaptive response which alter the gene expression of bacteria to aid resistance to antibiotics and environmental stress.
- Is formed by secretion of a polymeric matrix characterized by the expression of various factors like curli fimbriae and cellulose.
- Production of biofilm is regulated by csgD, a curli subunit gene which belongs to the group LuxR.
Type I and type III Secretion Systems
- Type I delivers a wide range of molecules like surface proteins, toxins, lipases and adenylate cyclase into the extracellular space of bacteria.
- Also type I helps in mediating adhesion and invasion into the immune cells of host and formation of biofilm.
- Two different surface-associated proteins, SiiE helps in the initial attachment to host cells which is followed by invasion and BapA which is responsible for adherence to host cells and biofilm formation are transmitted via a specialized Type I secretion system.
- Type III secretion system helps in translocating effector proteins from prokaryotic cytoplasm to the eukaryotic cytosol.

Fig 3: Virulence Factor of Salmonella Typhi
Source: https://www.intechopen.com/chapters/74829
Epidemiology and Transmission
Salmonella Typhi infections called Typhoid fever is a significant public health issue mainly prevalent in low and middle-income countries, especially in Sub-Saharan Africa, South/Southeast Asia. Mode of transmission of typhoid fever is human to human spread as these organisms lack a significant animal reservoir. Contaminated shellfish with raw sewage and production of canned meat with improper technique is related to disease outbreak. Salmonella is described as one of the four crucial causes of diarrhea in worldwide scenario, according to World Health Organization. About 1.35 million people are infected by Salmonella, with approximately about 420 deaths per year according to Centers for Disease Control and Prevention. Approximately around 200 million to 1 billion Salmonella infections are reported annually, among which 85% cases are associated with consumption of contaminated food. There is the estimation of decrease of cases globally since 2000, however it is still endemic among developing countries. Transmission is mainly through the fecal-oral route and factors related to transmission include socioeconomic status, population density, inadequate hygiene practices. In 2004, in Asia and Africa, it was estimated that 21.6 million cases were reported. Between year 2006 and 2010, about 500 cases were reported in UK. The enteric fever report was found to be high in specific regions of Sri Lanka like Vavuniya, Jaffna, Nuwara Eliya, Colomba and Kegalle. This pattern is connected to the consumption of water and food contaminated with feces. Likewise, inadequate sanitation and improper diet facilitate this outbreak. According to WHO, there are annually 9 million cases with about 110,000 deaths as per 2019. Elderly particularly those living in low-income groups and children aged between 5-9 years are at risk to infection by Salmonella.
Typhoid fever is mainly transmitted through fecal-oral route. Factors which are responsible for spread are:
- Contaminated Water: Drinking contaminated water can cause Salmonella related infection.
- Poor Sanitation: Living in unhygienic area and lack of proper sewage disposal systems increase the risk of infection.
- Food Handling: Having unhygienic food or consuming food prepared by those infected with bacteria cause infection.
Clinical Manifestations
The incubation period typically 1-3 weeks and symptoms can vary from mild to severe. The common symptoms include:
- Persistent and severe headache.
- Chills
- Loss of appetite leading to weight loss
- Discomfort and pain in abdomen
- Flat, red colored spots known as Rose spots on chest and stomach
- Cough
- Muscle pain and weakness
- Nausea and vomiting
- High fever up to 104ËšF
- Constipation or Diarrhea
If typhoid remains untreated then the complication may arise which are included below:
- Intestinal Perforation
- Internal Bleeding
- Neurological symptoms like confusion, delirium and seizures.
- Swollen or burst gallbladder
- Meningitis
- Oesteomyelitis
- Heart Inflammation
- Kidney Failure
- Bronchitis, pneumonia and other respiratory issues
- Miscarriage
Laboratory Diagnosis
Sample Collection
Depending on the site of infection and duration, sample is determined.
| Time | Sample |
| First week | Blood |
| Second week | Serum |
| Third week | Stool |
| Fourth week | Urine |
Gram Staining
- Appears as pink short rod cocco-bacilli.
Blood Culture
- The blood sample is to bile broth having ratio 1:10.
- Then the blood is inoculated and incubated.
- The blood culture bottles are checked for turbidity after 7 days.
- Bottle having growth are sub-cultured on solid media.
- On Blood Agar: 2-3mm in diameter, smooth white colonies, Non-hemolytic
- On MacConkey Agar: colorless colonies
- On XLD Agar: smooth, red in color with black center colony.
- On SS Agar: smooth, colorless colonies with black spot.
Biochemical Tests
- After culture, colonies from incubated plates are performed for biochemical test and are confirmed as Salmonella Typhi.
Slide Agglutination Test
- A milky suspension of culture is prepared with saline.
- Then a drop is poured in reaction circles i.e. O, H, AH, BH.
- After that, the circle is observed for agglutination.
Treatments
Treatment of typhoid fever is only by use of antibiotics. The commonly prescribed antibiotics are:
- Fluoroquinolones: Antibiotics like ciprofloxacin, levofloxacin, or ofloxacin are used as a first choice for treatment of infection with Salmonella.
- Macrolides: Azithromycin is used in case of antibiotic resistance Salmonellosis.
- Cephalosporins: Ceftriaxone, cefotaxime or cefixime are used in antibiotic resistance case.
- Carbapenems: used to treat serious typhoid fever.
Steroids such as dexamethasone is used if the case is severe.
Prevention and Control
- Proper sanitation: proper waste disposal, hand washing with soap and water and education on importance of sanitation and hygiene can significantly reduce the typhoid spread.
- Practicing Food Safety: consuming thoroughly cooked food, avoiding contaminated and raw food, and practicing safe food handling practices plays important role in prevention of spread of typhoid.
- Personal Hygiene: Not sharing utensils like cup, plates or food with person having infections, keeping bathrooms clean can prevent typhoid spread.
- Consumption of clean and contamination free water is crucial to avoid typhoid infection.
- Vaccination can be useful for those travelling to or living in highly risk areas.
Antibiotic Resistance
The origin of resistance against antibiotic is still unclear however the mechanism of antibiotic resistance in S. Typhi is mediated by:
- Mutation on chromosome
- Acquisition of foreign genes through plasmids
- Inactivation of the antibiotics
- Efflux or transport of the antibiotics
- Reduced permeability of the antibiotics
- Modification of antibiotic target site
Horizontal acquisition of resistance genes, mobilized through insertion sequences, transposons and conjugative plasmids, recombination of foreign DNA into chromosome, and mutations in different chromosomal loci are responsible for resistance against antibiotic. Chloramphenicol resistance encoded by plasmid was first observed in the early 1970s which was then followed by large epidemics in Central America. Ampicillin was then used for elimination of carrier state and for therapy but soon plasmid-encoded resistance was developed. Then, Co-trimoxazole was used for treatment but shortly plasmid-encoded resistance was developed. Salmonella enterica serovar Typhi carrying plasmid-encoded resistance against Ampicillin, Co-trimoxazole and Chloramphenicol first case was reported from South East Asia.
Conclusion
Salmonella is one of the leading bacterium that causes food poisoning in humans and is leading cause of typhoid fever which is a life-threatening illness. Typhoid fever is responsible for a significant public health issue worldwide and is commonly found in raw or undercooked meat products as well as in fruits and vegetables that are contaminated with human feces. Symptoms may vary from mild headache, vomiting, nausea to severe conditions like meningitis, oesteomyelitis and kidney failure.
References
Wang, W. (2022). Salmonella typhi characteristics and cultural methods. Journal of Plant Pathology & Microbiology, 13(12), 651. https://doi.org/10.35248/2157-7471.22.13.651
Elsevier. (n.d.). Salmonella typhi. In ScienceDirect Topics. Retrieved February 11, 2026, from https://www.sciencedirect.com/topics/agricultural-and-biological-sciences/salmonella-typhi
Astié, V., Millon, C., Decams, J.-M., & Bartasyte, A. (2019). Direct liquid injection chemical vapor deposition. In Chemical vapor deposition for nanotechnology. IntechOpen. https://doi.org/10.5772/intechopen.80244
Lamichhane, B., Mawad, A. M. M., Saleh, M., Kelley, W. G., Harrington II, P. J., Lovestad, C. W., Amezcua, J., Sarhan, M. M., El Zowalaty, M. E., Ramadan, H., & … (2024). Salmonellosis: An overview of epidemiology, pathogenesis, and innovative approaches to mitigate the antimicrobial resistant infections. Antibiotics, 13(1), Article 76. https://doi.org/10.3390/antibiotics13010076
Sultana, R. R., Zafarullah, S. N., & Kirubamani, N. H. (2018). Deficiency of folate in pregnancy on diverse subjects using FTIR spectroscopy. In B-Group Vitamins – Current Uses and Perspectives (Chap. 6). IntechOpen. https://doi.org/10.5772/intechopen.74829
Epidemiology Unit, Ministry of Health, Nutrition & Indigenous Medicine, Sri Lanka. (2013, October 19–25). Weekly epidemiological report: Vol. 40, No. 43 [PDF]. https://www.epid.gov.lk/storage/post/pdfs/vol_40_no_43_english.pdf
World Health Organization. (2023, March 30). Typhoid. https://www.who.int/news-room/fact-sheets/detail/typhoid
AJ Hospital and Research Centre. (2024, June 25). Typhoid: Symptoms, transmission, and prevention. https://www.ajhospital.in/news/typhoid-symptoms-transmission-and-prevention
Cleveland Clinic. (2022, September 7). Typhoid fever: Causes, symptoms & treatment. https://my.clevelandclinic.org/health/diseases/17730-typhoid-fever
Crump, J. A., Sjölund-Karlsson, M., Gordon, M. A., & Parry, C. M. (2015). Epidemiology, clinical presentation, laboratory diagnosis, antimicrobial resistance, and antimicrobial management of invasive Salmonella infections. Clinical Microbiology Reviews, 28(4), 901–937. https://doi.org/10.1128/CMR.00002-15
Mayo Clinic. (2025, December 24). Typhoid fever — Diagnosis & treatment. https://www.mayoclinic.org/diseases-conditions/typhoid-fever/diagnosis-treatment/drc-20378665
Khudhair, H. A. M., Mahdi, M. S., Ameen, R. S., & Yasear, A. Y. (2020). Identification and laboratory diagnosis of Salmonella typhi isolates from patients suffering from typhoid fever in Iraq.Plant Archives,20(2), 3823–3829. https://www.plantarchives.org/20-2/3823-3829%20(6950).pdf
Ugboko, H., & De, N. (2014). Mechanisms of antibiotic resistance in Salmonella typhi. International Journal of Current Microbiology and Applied Sciences, 3(12), 461–476.